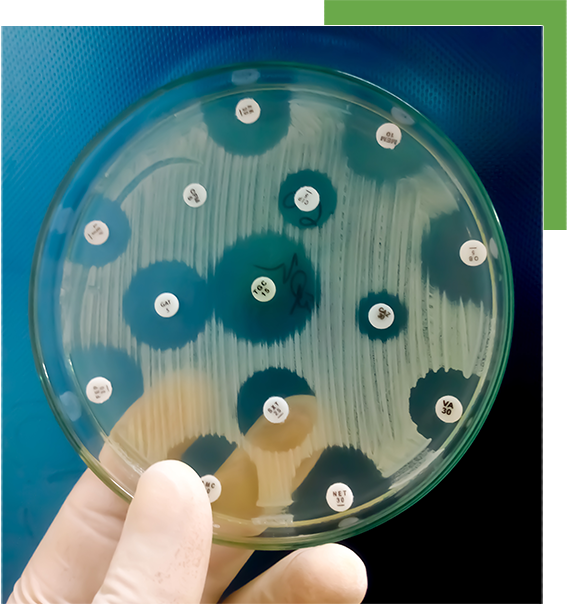

LES NORMES DU SOIN DES PLAIES AVEC DEBRICHEM®
Notre produit est un agent topique déshydratant innovant conçu pour éliminer l’infection et le biofilm dans les plaies difficiles à cicatriser, en une seule application de 60 secondes.

UN ALLIÉ PUISSANT CONTRE
LE BIOFILM ET L’INFECTION
POURQUOI DEBRICHEM®
Une méthode nouvelle, disruptive et extrêmement efficace pour éliminer le biofilm et l’infection en quelques secondes en une seule application.
ÉLIMINE L’INFECTION
ET LE BIOFILM
RESTEZ INFORMÉ
ABONNEZ-VOUS AUX ACTUALITÉS
AVANTAGES CLÉS
DE L’UTILISATION DE DEBRICHEM®
APPLICATION UNIQUE
Dans plus de 90 % des cas, la granulation est obtenue après une seule application de DEBRICHEM®, ce qui fait gagner du temps pendant le traitement et accélère la cicatrisation.1 2
SIMPLE ET RAPIDE À UTILISER
Grâce à son action rapide et à sa facilité d’emploi en dehors du bloc opératoire, DEBRICHEM® peut être intégré sans effort aux protocoles standards de soin des plaies par les professionnels de santé médicaux et paramédicaux.3
SANS DANGER POUR LA PEAU INTACTE
DEBRICHEM® works by withdrawing water from the wound bed materials and due to the low water content of the outer layer of the epidermis, the surrounding healthy skin is not affected.4
EFFECTIVE FOR ALL
IDÉAL CONTRE LA RÉSISTANCE AUX ANTIBIOTIQUES
DEBRICHEM® is a dynamic wound care innovation that is ideal for all patients, including those facing antibiotic-resistant challenges. Its chemistry is designed to combat infection without resistance, offering a lasting solution where traditional antibiotics fall short.
Economical and efficient, DEBRICHEM® simplifies treatment, reduces dependency on costly antibiotics, and accelerates healing across the spectrum of patient needs.
RÉDUIT LA DOULEUR DES PLAIES CHRONIQUES
Chronic pain is a major issue for patients living with hard-to-heal wounds. Pain is caused by the infection and inflammation of the wound. By eliminating the infection, patients experience a significant decrease in pain soon after DEBRICHEM® treatment.2

DEBRICHEM®
PROCÉDURE D’APPLICATION
ÉLIMINE LE BIOFILM & L’INFECTION
DEBRICHEM® propose un protocole simple et rapide, adapté aux soins ambulatoires, à l’hospitalisation complète, hôpital de jour, hospitalisation à domicile ; accessible aux professionnels de santé médicaux et paramédicaux : médecins et infirmiers. Contrairement aux méthodes de débridement traditionnelles, il ne requiert aucune formation spécifique.
UNE SOLUTION RAPIDE ET EFFICACE
POUR LES PLAIES DIFFICILES À CICATRISER
QUAND ENVISAGER DEBRICHEM®
DEBRICHEM® can be used by all healthcare professionals in particular wound care specialists, nurses, surgeons, diabetic foot ulcer specialists and vulnologists, to treat all non-surgical hard-to-heal wounds such as:

ulcères du pied diabétique

ulcères veineux

ulcères cutanés post-traumatiques

escarres (ulcères de pression)
DEMANDER UNE DÉMONSTRATION
SI VOUS ENVISAGEZ DEBRICHEM® POUR VOTRE PRATIQUE CLINIQUE.
PRENEZ CONTACT AVEC L’UN DE NOS REPRÉSENTANTS COMMERCIAUX POUR UNE DÉMONSTRATION.
COMMENT DEBRICHEM® FONCTIONNE
DEBRICHEM® déshydrate le biofilm ainsi que les micro-organismes résidents et planctoniques en 60 secondes d’application.
En capturant instantanément les molécules d’eau de tout matériau biologique exposé, DEBRICHEM® produit un effet déshydratant immédiat sans endommager les tissus viables situés sous le lit de la plaie.
VIDÉO 1: mode d’action de DEBRICHEM® sur un modèle de plaie animé
VIDÉO 2: effet de DEBRICHEM® sur les bactéries
VIDÉO 3: innocuité de DEBRICHEM® sur la peau intacte
VIDÉO 4: procédure d’application de DEBRICHEM®

POURQUOI DEBRICHEM® EST SÛR POUR LA PEAU SAINE
À l’inverse, les tissus viables et la peau saine sont protégés par des lipides membranaires, qui présentent une teneur en eau plus faible.
Cela protège la couche épidermique de la peau environnante de l’effet de dessiccation.
Le biofilm est constitué à 97 % de molécules d’eau et d’agrégats microbiens. Il est enveloppé dans une matrice extracellulaire de polysaccharides, de protéines et de glycoprotéines.
SOLUTION ÉCONOMIQUE
Des études ont montré que DEBRICHEM® est une solution 57 % plus rentable que les standards de soin des plaies. Il pourrait permettre aux systèmes de santé d’économiser des millions.3

FRÉQUEMMENT POSÉES
QUESTIONS
1Qu’est-ce que DEBRICHEM®?
Agent topique déshydratant destiné au débridement non chirurgical et au traitement des plaies infectées ne nécessitant pas de chirurgie. Le produit doit être appliqué uniquement par des professionnels de santé.
2Pourquoi DEBRICHEM® est-il sûr sur une peau intacte ?
Le biofilm est composé à 97 % de molécules d’eau et d’agrégats microbiens. DEBRICHEM® se lie aux molécules d’eau. Son principe actif acide se dissocie et libère des protons et des anions qui captent l’eau et libèrent de l’énergie, déclenchant une déshydratation fortement exothermique. En capturant instantanément l’eau de tout matériau biologique exposé, DEBRICHEM® produit un effet déshydratant immédiat sans endommager les tissus (viables) sains sous-jacents.
3Quelle est l'indication de DEBRICHEM®?
DEBRICHEM® peut être utilisé pour traiter toutes les plaies difficiles à cicatriser ne nécessitant pas de chirurgie :
- Diabetic Foot Ulcers
- Venous Leg Ulcers
- Pressure Ulcers
- Vasculitis Ulcers
- Post-surgical Ulcers
- Post-traumatic Skin Ulcers
- Arterial Ulcers
- Schemic ulcers prior to an effective revascularization.
- Neoplastic Ulcers.
- Underlying abscesses or fasciitis which require lancing.
- Underlying osteomyelitis.
- Intolerance for any of the ingredients.
- Allergies to any of the ingredients.
- The safety and performance of DEBRICHEM® has not been substantiated in pediatric subgroups and in pregnant or lactating women. Physicians should consider alternative options for debridement in these patients.
- Underlying cartilage.
- Dry full thickness non-viable tissue (eschar), unless removed pre-debridement.
- ulcères du pied diabétique
- ulcères veineux de jambe
- escarres
- ulcères de vascularite
- ulcères post-chirurgicaux
- ulcères cutanés post-traumatiques
- ulcères artériels
- ulcères ischémiques avant revascularisation efficace
- ulcères néoplasiques
- abcès sous-jacents ou fasciite nécessitant une incision
- ostéomyélite sous-jacente
- intolérance à l’un des composants
- allergies à l’un des composants
- La sécurité et l’efficacité de DEBRICHEM® n’ont pas été établies chez les enfants ni chez les femmes enceintes ou allaitantes. Les médecins doivent envisager d’autres méthodes de débridement pour ces patientes.
- cartilage sous-jacent
- Tissu non viable sec sur toute son épaisseur (escarre), sauf s'il a été retiré avant le débridement.
4Puis-je utiliser DEBRICHEM® avec la thérapie par pression négative (TPN) ?
Associé à la TPN, DEBRICHEM® élimine efficacement le biofilm et la nécrose et favorise le développement rapide du tissu de granulation, accélérant ainsi la cicatrisation. Une étude récente menée auprès de douze patients présentant divers ulcères du pied et de la jambe le démontre : lésions de 308 cm² en moyenne évoluant depuis 13 mois ; cinq ulcères veineux, deux ulcères artériels, un ulcère mixte veineux/artériel et trois ulcères post-traumatiques d’étiologie inconnue. Tous les patients ont obtenu une granulation complète en 13,2 jours en moyenne.